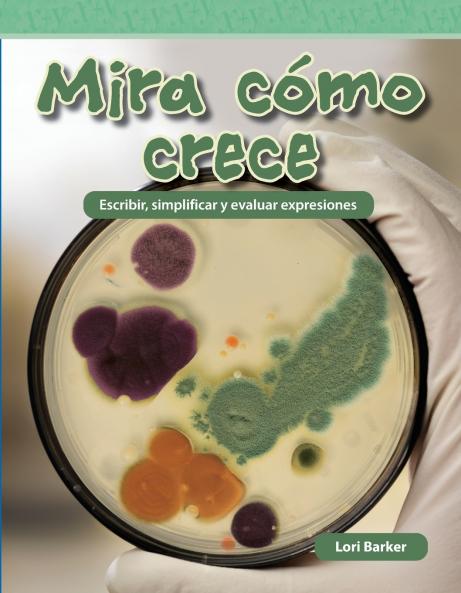
Mira c mo crece

Spanish
Paperback
₹708
₹1248
43.27% OFF
(All inclusive*)
Delivery Options
Please enter pincode to check delivery time.
*COD & Shipping Charges may apply on certain items.
Review final details at checkout.
Looking to place a bulk order? SUBMIT DETAILS
Delivery Options
Please enter pincode to check delivery time.
*COD & Shipping Charges may apply on certain items.
Review final details at checkout.
About The Book
Description
Author
Learn how scientists use algebraic expressions and exponential form to explore the growth of amoebas euglenas and bacteria! This book features engaging practice problems encouraging Spanish readers to practice more advanced mathematical concepts.
Details
ISBN 13
9798765960493
Publication Date
-02-04-2024
Pages
-34
Weight
-72 grams
Dimensions
-178x229x2.24 mm